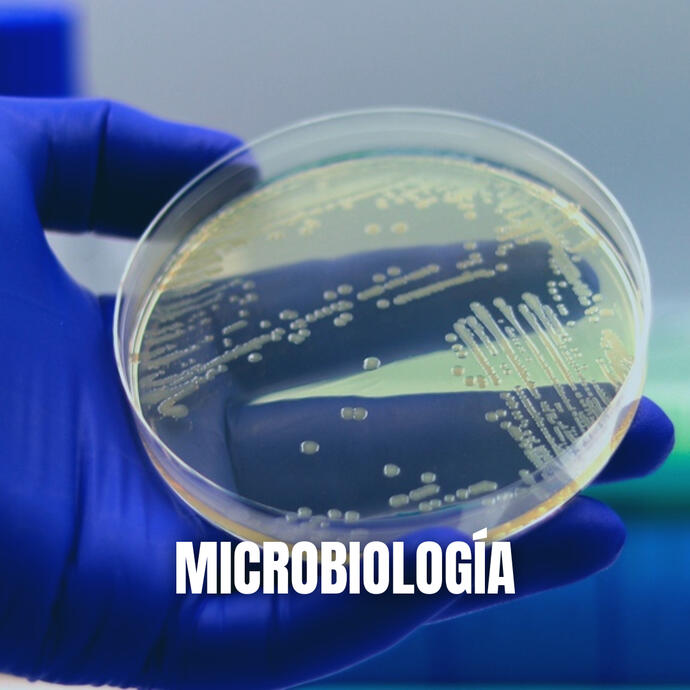

Laboratorio san pedro
LABORATORIO DE ANALISIS "SAN PEDRO", ES UNA EMPRESA HUAMANTLECA DEDICADA A REALIZAR ANALISIS CLINICOS CON LA SEGURIDAD, CONFIANZA Y CALIDAD QUE USTED SE MERECE
Nuestros Servicios
Nuestros Horarios
Lunes a viernes 7:00 am a 7:00 pm
Sábado 7:00 am a 3:00 pm
Domingo 7:00 am a 12:00 pm
Visítanos
Hidalgo Pte. #301-A, Colonia Centro, Huamantla, Tlaxcala
© Laboratorio San Pedro S.A. All rights reserved.